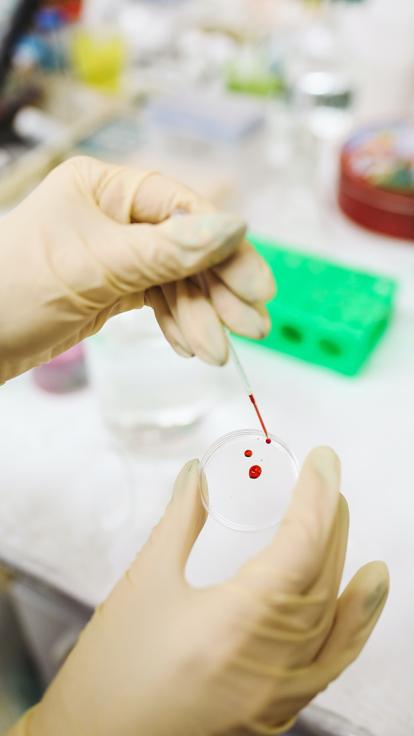
1_bloed_handen

Welke informatie kun je uit bloed halen?
Ook interessant om te weten
In samenwerking met:
OLVG - Ziekenhuis met een hart
BNNVARA

Laatste update: 04-07-2023
Gemiddeld heeft een volwassen vrouwenlichaam 4,5 liter bloed en een volwassen mannenlichaam 5,6 liter bloed.
Je kan veel informatie uit bloed halen, denk aan:
Of je ziektes of virussen bij je draagt
Of je organen goed functioneren
Je DNA
Je bloedgroep
Of je genoeg vitaminen en mineralen hebt
Of je de juiste dosering van een geneesmiddel gebruikt

Bloed bestaat uit bloedplasma, rode bloedcellen en witte bloedcellen. Uit elk bestanddeel kan andere informatie worden gehaald.
Om deze informatie uit je bloed te halen doe je een bloedonderzoek. Er wordt dan eerst bloed bij je afgenomen. Dit gebeurt op een prikpost of direct op de Eerste Hulp.
Na het bloedprikken gaat je bloed naar het laboratorium. Daar worden de bestanddelen van elkaar gescheiden met machines.
Veelvoorkomende bloedonderzoeken zijn:
Bezinkingssnelheid (BSE): Heb je ontstekingen?
T4: Werkt je schildklier goed?
Glucosespiegels: Heb je bijvoorbeeld diabetes?
Hemoglobinegehalte (Hb): Heb je bloedarmoede?
CRP: Hoe hoog is de ontstekingswaarde?

Bloedplasma vervoert stoffen zoals vitamines, hormonen en eiwitten. Daarnaast zorgt het voor het opwarmen en afkoelen van je lichaam.
Het plasma zou doorzichtig moeten zijn. Als dit niet zo is dan heb je mogelijk te veel vetten in je bloed. Wat een risico op hart- en vaatziekten kan betekenen.

Rode bloedcellen vervoeren zuurstof en koolstofdioxide naar de longen.
Als je bijvoorbeeld weinig energie hebt kan een arts onderzoeken hoeveel rode bloedcellen je hebt. Een tekort kan namelijk voor vermoeidheid zorgen.

Witte bloedcellen beschermen je lichaam onder andere tegen schadelijke virussen en schimmels.
Daardoor kun je aan de hand van witte bloedcellen bijvoorbeeld aantonen hoe het gaat met iemands weerstand. Bij een slechte weerstand kan je sneller ziek worden dan normaal.
Tijdens een bloedonderzoek kunnen ze ook meten hoeveel medicijnen of drugs er in je bloed aanwezig zijn.

Artsen kunnen dus allerlei informatie uit je bloed halen. Aan de hand van deze informatie kunnen ze conclusies trekken en bepalen of en wat voor medicijnen of behandelingen je nodig hebt.
Kan jij tegen bloedprikken?
Welke informatie kun je uit bloed halen?





